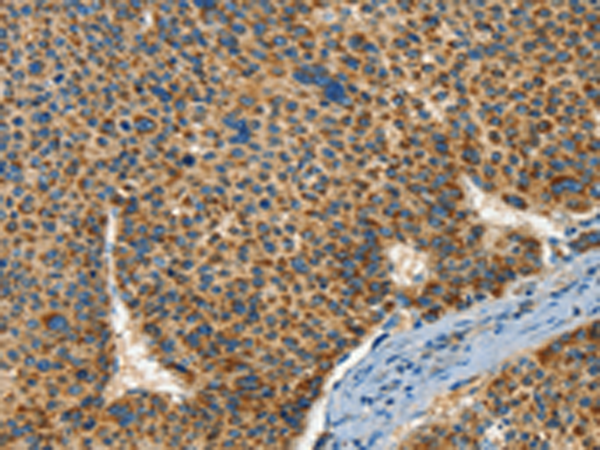

中文名稱: 兔抗IFT74多克隆抗體
英文名稱: Anti-IFT74 rabbit polyclonal antibody
克隆類型: rabbit polyclonal
技術(shù)規(guī)格
|
Background: |
Capillary morphogenesis protein 1 (CMG1), also known as intraflagellar transport protein 74 (ITP74) or coiled-coil domain-containing protein 2 (CCDC2), is a 600 amino acid human homologue of IFT-71, a complex B protein supporting intraflagellar transport (IFT) in Chlamydomonas. CMG1 localizes to the cytoplasmic vesicle and is highly expressed in adult and fetal kidney and testis, with lower levels of expression in adult heart, placenta, lung, liver and pancreas, and in fetal heart, lung and liver. CMG1 has been suggested to have a role in the primary cilia of HUVEC, and it also functions as a transcriptional regulator of cyclin D2 in spermatocyte-derived cells. |
|
Applications: |
ELISA, IHC |
|
Name of antibody: |
IFT74 |
|
Immunogen: |
Synthetic peptide of human IFT74 |
|
Full name: |
intraflagellar transport 74 homolog (Chlamydomonas) |
|
Synonyms: |
CMG1; CCDC2; CMG-1 |
|
SwissProt: |
Q96LB3 |
|
ELISA Recommended dilution: |
1000-5000 |
|
IHC positive control: |
Human liver cancer and Human breast cancer |
|
IHC Recommend dilution: |
50-200 |
購物車
幫助
021-54845833/15800441009
